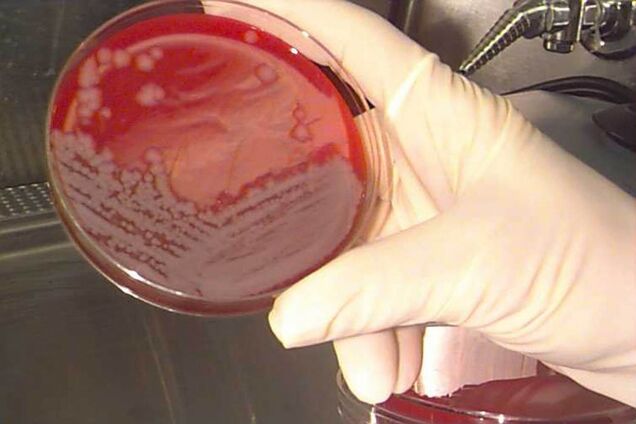
Украинцы выезжают в Европу, чтобы сделать прививку от смертельной инфекции

Во Львове врачи удалили из глаза мужчины 12-сантиметрового гельминта: заразился из-за укуса комара на отдыхе. Фото
В Японии вспыхнула болезнь, убивающая человека за 48 часов: что известно
Стрептококк группы А обычно передается воздушно-капельным и контактным путем
Профессор Волоха: обезьянья оспа может попасть в Украину, но привитым не стоит волноваться. Интервью
Медик объяснила, для кого новый вирус представляет наибольшую угрозу
В Европе и США зафиксировали загадочную детскую болезнь: один ребенок умер
Гепатит неизвестного происхождения поражает детей в 12 странах